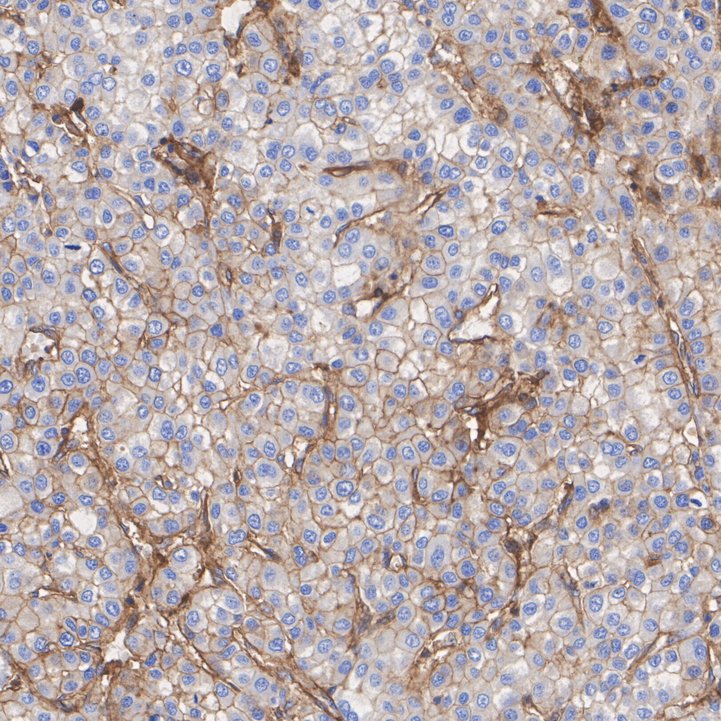
HA750347_5.jpg

MHC class I Recombinant Rabbit Monoclonal Antibody [JF10-38]

cat.: HA750347
| Product Type: | Recombinant Rabbit monoclonal IgG, primary antibodies |
|---|---|
| Species reactivity: | Human |
| Applications: | WB, IF-Cell, IHC-P, FC, IF-Tissue |
| Clonality: | Monoclonal |
| Clone number: | JF10-38 |
| Form: | Liquid |
| Storage condition: | Store at +4℃ after thawing. Aliquot store at -20℃ or -80℃. Avoid repeated freeze / thaw cycles. |
| Storage buffer: | 1*PBS (pH7.4). |
| Concentration: | 1ug/ul |
| Purification: | Protein A affinity purified. |
| Molecular weight: | Predicted band size: 41 kDa |
| Isotype: | IgG |
| Immunogen: | Synthetic peptide within Human HLA aa 263-299 / 365. |
| Positive control: | A431 cell lysate, HL-60 cell lysate, Jurkat cell lysate, Raji cell lysate, THP-1 cell lysate, HL-60, human colon cancer tissue, human liver cancer tissue, human tonsil tissue, human pancreas tissue. |
| Subcellular location: | Cell membrane. |
| Recommended Dilutions:
WB IF-Cell IHC-P FC IF-Tissue |
1:1,000-1:2,000 1:100 1:200-1:1:1,000 1:1,000 1:200 |
| Uniprot #: | SwissProt: P04439 Human | P01889 Human |
| Alternative names: | A 28 A 9 Antigen presenting molecule Aw 24 Aw 68 CLASS I HISTOCOMPATIBILITY ANTIGEN H2 K1 H2K HLA A HLA class I histocompatibility antigen A 1 alpha chain HLA class I histocompatibility antigen A 11 alpha chain HLA class I histocompatibility antigen A 2 alpha chain HLA class I histocompatibility antigen A 24 alpha chain HLA class I histocompatibility antigen A 3 alpha chain HLA class I histocompatibility antigen A 30 alpha chain HLA class I histocompatibility antigen A 32 alpha chain HLA class I histocompatibility antigen A 68 alpha chain HLAA Leukocyte antigen class I A Major histocompatibility complex class I A MHC class I antigen A 1 MHC class I antigen A*11 MHC class I antigen A*2 MHC class I antigen A*24 MHC class I antigen A*3 MHC class I antigen A*30 MHC class I antigen A*32 MHC class I antigen A*68 MHC class I antigen HLA A heavy chain MHC class I heavy chain H2 K |
Images

|
Fig1:
Western blot analysis of MHC class I on different lysates with Rabbit anti-MHC class I antibody (HA750347) at 1/1,000 dilution. Lane 1: A431 cell lysate Lane 2: HL-60 cell lysate Lane 3: K-562 cell lysate (low expression) Lane 4: Jurkat cell lysate Lane 5: Raji cell lysate Lane 6: THP-1 cell lysate Lysates/proteins at 20 µg/Lane. Predicted band size: 41 kDa Observed band size: 45 kDa Exposure time: 1 minute; ECL: K1801; 4-20% SDS-PAGE gel. Proteins were transferred to a PVDF membrane and blocked with 5% NFDM/TBST for 1 hour at room temperature. The primary antibody (HA750347) at 1/1,000 dilution was used in 5% NFDM/TBST at 4℃ overnight. Goat Anti-Rabbit IgG - HRP Secondary Antibody (HA1001) at 1/50,000 dilution was used for 1 hour at room temperature. |

|
Fig2:
Western blot analysis of MHC class I on different lysates with Rabbit anti-MHC class I antibody (HA750347) at 1/2,000 dilution. Lane 1: HAP1-parental cell lysate Lane 2: HAP1-MHC class I KD cell lysate Lysates/proteins at 10 µg/Lane. Predicted band size: 41 kDa Observed band size: 41 kDa Exposure time: 30 seconds; ECL: K1801; 4-20% SDS-PAGE gel. Proteins were transferred to a PVDF membrane and blocked with 5% NFDM/TBST for 1 hour at room temperature. The primary antibody (HA750347) at 1/2,000 dilution was used in primary antibody dilution (K1803) at 4℃ overnight. Goat Anti-Rabbit IgG - HRP Secondary Antibody (HA1001) at 1/50,000 dilution was used for 1 hour at room temperature. |

|
Fig3:
Immunocytochemistry analysis of HL-60 cells and K-562 (low expression) labeling MHC class I with Rabbit anti-MHC class I antibody (HA750347) at 1/100 dilution. Cells were fixed in 4% paraformaldehyde for 20 minutes at room temperature, permeabilized with 0.1% Triton X-100 in PBS for 5 minutes at room temperature, then blocked with 1% BSA in 10% negative goat serum for 1 hour at room temperature. Cells were then incubated with Rabbit anti-MHC class I antibody (HA750347) at 1/100 dilution in 1% BSA in PBST overnight at 4 ℃. Goat Anti-Rabbit IgG H&L (iFluor™ 488, HA1121) was used as the secondary antibody at 1/1,000 dilution. PBS instead of the primary antibody was used as the secondary antibody only control. Nuclear DNA was labelled in blue with DAPI. Beta tubulin (M1305-2, red) was stained at 1/100 dilution overnight at +4℃. Goat Anti-Mouse IgG H&L (iFluor™ 594, HA1126) was used as the secondary antibody at 1/1,000 dilution. |

|
Fig4:
Immunohistochemical analysis of paraffin-embedded human colon cancer tissue with Rabbit anti-MHC class I antibody (HA750347) at 1/1,000 dilution. The section was pre-treated using heat mediated antigen retrieval with Tris-EDTA buffer (pH 9.0) for 20 minutes. The tissues were blocked in 1% BSA for 20 minutes at room temperature, washed with ddH2O and PBS, and then probed with the primary antibody (HA750347) at 1/1,000 dilution for 1 hour at room temperature. The detection was performed using an HRP conjugated compact polymer system. DAB was used as the chromogen. Tissues were counterstained with hematoxylin and mounted with DPX. |
|
Fig5:
Immunohistochemical analysis of paraffin-embedded human liver cancer tissue with Rabbit anti-MHC class I antibody (HA750347) at 1/200 dilution. The section was pre-treated using heat mediated antigen retrieval with Tris-EDTA buffer (pH 9.0) for 20 minutes. The tissues were blocked in 1% BSA for 20 minutes at room temperature, washed with ddH2O and PBS, and then probed with the primary antibody (HA750347) at 1/200 dilution for 1 hour at room temperature. The detection was performed using an HRP conjugated compact polymer system. DAB was used as the chromogen. Tissues were counterstained with hematoxylin and mounted with DPX. |

|
Fig6:
Immunohistochemical analysis of paraffin-embedded human tonsil tissue with Rabbit anti-MHC class I antibody (HA750347) at 1/1,000 dilution. The section was pre-treated using heat mediated antigen retrieval with Tris-EDTA buffer (pH 9.0) for 20 minutes. The tissues were blocked in 1% BSA for 20 minutes at room temperature, washed with ddH2O and PBS, and then probed with the primary antibody (HA750347) at 1/1,000 dilution for 1 hour at room temperature. The detection was performed using an HRP conjugated compact polymer system. DAB was used as the chromogen. Tissues were counterstained with hematoxylin and mounted with DPX. |

|
Fig7:
Immunohistochemical analysis of paraffin-embedded human pancreas tissue with Rabbit anti-MHC class I antibody (HA750347) at 1/200 dilution. The section was pre-treated using heat mediated antigen retrieval with Tris-EDTA buffer (pH 9.0) for 20 minutes. The tissues were blocked in 1% BSA for 20 minutes at room temperature, washed with ddH2O and PBS, and then probed with the primary antibody (HA750347) at 1/200 dilution for 1 hour at room temperature. The detection was performed using an HRP conjugated compact polymer system. DAB was used as the chromogen. Tissues were counterstained with hematoxylin and mounted with DPX. |

|
Fig8:
Immunofluorescence analysis of paraffin-embedded human tonsil tissue labeling MHC class I with Rabbit anti-MHC class I antibody (HA750347) at 1/200 dilution. The section was pre-treated using heat mediated antigen retrieval with Tris-EDTA buffer (pH 9.0) for 20 minutes. The tissues were blocked in 10% negative goat serum for 1 hour at room temperature, washed with PBS, and then probed with the primary antibody (HA750347, green) at 1/200 dilution overnight at 4 ℃, washed with PBS. Goat Anti-Rabbit IgG H&L (iFluor™ 488, HA1121) was used as the secondary antibody at 1/1,000 dilution. Nuclei were counterstained with DAPI (blue). |

|
Fig9:
Flow cytometric analysis of HL-60 cells labeling MHC class I. Cells were fixed and permeabilized. Then stained with the primary antibody (HA750347, 1μg/mL) (red) compared with Rabbit IgG Isotype Control (green). After incubation of the primary antibody at +4℃ for an hour, the cells were stained with a iFluor™ 488 conjugate-Goat anti-Rabbit IgG Secondary antibody (HA1121) at 1/1,000 dilution for 30 minutes at +4℃. Unlabelled sample was used as a control (cells without incubation with primary antibody; black). |
Note: All products are “FOR RESEARCH USE ONLY AND ARE NOT INTENDED FOR DIAGNOSTIC OR THERAPEUTIC USE”.